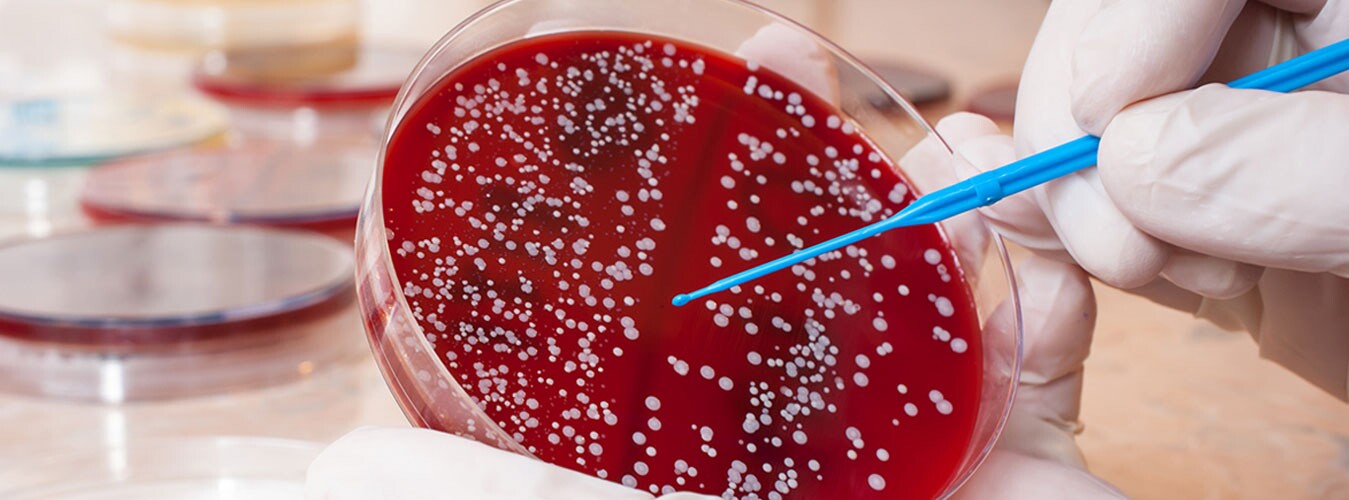
سرطان خون و همه چیز درباره نشانه های آن سرطان خون و همه چیز درباره نشانه های آن

عصر ایران- علائم بسته به نوع سرطان خون از لوسمی گرفته تا لنفوم، میلوم، MDS، MPN یا سایر انواع سرطان ها و اختلالات خونی متفاوت هستند.
در ادامه برخی از علائم رایج سرطان خون با استناد به یافته های منتشر شده توسط بنیاد سرطان خون استرالیا توضیح داده شده اند. البته باید توجه داشته باشیم که یک سری از نشانه ها ممکن است در رنگ های مختلف پوست متفاوت به نظر برسند.

- علت: تجمع سلول های سرطانی و واکنش بدن به آنها می تواند متابولیسم بدن را تغییر و حجم ماهیچه ها و چربی ها را کاهش دهد.
- آنچه باید انتظار داشته باشیم: کاهش وزنی که بر اساس رژیم غذایی و ورزش فعلی ما غیر عادی به نظر می رسد.

- علت: سطح پایین پلاکت ها که به لخته شدن خون کمک می کنند.
- آنچه باید انتظار داشته باشیم: در چنین حالتی ممکن است خونریزی از بینی یا لثه، خونریزی طولانی مدت ناشی از بریدگی، پریودهای سنگین و خون در ادرار یا مدفوع وجود داشته باشد.
در موارد بسیار نادر، بیمار با احتمال خونریزی در مغز رو به رو است که می تواند باعث علائم عصبی شود.
احتمال دیگر پتشی است که لکه های خونی قرمز کوچک و برجسته زیر پوست که اغلب از پاها شروع می شوند، به شمار می رود.
در پوست هایی که رنگ تیره تری دارند، این لکه ها پر رنگ تر از پوست اطراف ظاهر می شوند.

- علت: تجمع غیر طبیعی گلبول های سفید در غدد لنفاوی.
- آنچه باید انتظار داشته باشیم: به احتمال زیاد بیمار این موارد را در گردن، زیر بغل یا ناحیه کشاله ران خود مشاهده خواهد کرد. توده ها معمولا بدون درد هستند، هرچند برخی از افراد احساس درد می کنند.
اگر توده ها یا نقاط متورم داخل بدن وجود داشته باشند و به اندام هایی مانند ریه ها فشار وارد کنند، ممکن است باعث درد، ناراحتی یا تنگی نفس شوند.

- علت: آنمی (سطح پایین گلبول های قرمز خون).
- آنچه باید انتظار داشته باشیم: تنگی نفس حتی زمانی که در فرد حال استراحت است، احساس ضعف یا سبکی سر و ضربان قلب سریع یا نامنظم.

- علت: نامعلوم
- آنچه باید انتظار داشته باشیم: برخی از افراد مبتلا به لنفوم یا لوسمی دچار تعریق شبانه می شوند اما همچنان علت علمی دقیق این موضوع مشخص نیست.

- علت: سطح پایین گلبول های سفید خون که با عفونت مبارزه می کنند.
- آنچه باید انتظار داشته باشیم: عفونت های مداوم، مکرر یا شدید که با نشانه های مشابه سرماخوردگی مانند لرز، سرفه و گلودرد همراه هستند. همچنین می توان به زخم های دهانی اشاره کرد که به راحتی از بین نمی روند.

- علت: سطح پایین گلبول های سفید خون که با عفونت مبارزه می کنند.
- آنچه باید انتظار داشته باشیم: تب 38 درجه سانتیگراد یا بالاتر حتی اگر هیچ نشانه آشکار دیگری از عفونت فعال وجود نداشته باشد.

- علت: بثورات پوستی می تواند به دلیل سطح پایین پلاکت ها ایجاد شود. برخی از افراد مبتلا به سرطان خون خارش شدیدی را تجربه می کنند، اما دانشمندان همچنان به طور کامل نمی دانند که چه چیزی باعث این مشکل می شود.
- آنچه باید انتظار داشته باشیم: ممکن است بیمار متوجه لکه های قرمز کوچک روی پوست (پتشی) یا بثورات بنفش (پورپورا) شود.
پتشی و پورپورا ضایعاتی هستند که با فشردن محو نمی شوند.خارش ناشی از لنفوم می تواند شدید باشد و همچنین ممکن است باعث احساس سوزش شود.

- علت: آسیب به استخوان ها (استخوان و مفاصل) و تجمع غیر طبیعی سلول های خونی در طحال (درد شکمی).
- آنچه باید انتظار داشته باشیم: میلوم می تواند باعث درد در هر یک از استخوان های اصلی مانند پشت، دنده یا باسن شود.
همچنین ممکن است بیمار تنها بعد از خوردن مقدار کمی غذا احساس سیری و درد و ناراحتی زیر دنده های خود در سمت چپ کند. به این علائم می توان نفخ و دل درد را نیز اضافه کرد.

- علت: آنمی (سطح پایین گلبول های قرمز خون).
- آنچه باید انتظار داشته باشیم: خستگی که با استراحت یا خواب از بین نمی رود و همچنین احساس ضعف و سردرد.

- علت: آنمی (سطح پایین گلبول های قرمز خون).
- آنچه باید انتظار داشته باشیم: رنگ پریدگی غیر معمول به همراه احساس ضعف و سردرد.
افرادی که پوست تیره تری دارند ممکن است خاکستری رنگ به نظر آمده و کف دست هایشان نیز کم رنگ تر از سایر نواحی باشد.
- علت: سطح بسیار بالای گلبول های سفید خون. برخی از انواع سرطان خون مانند لوسمی حاد میلوئیدی (AML) خیلی سریع پیشرفت کرده و ممکن است وضعیت بیمار را به طور ناگهانی بسیار وخیم کند.
- آنچه باید انتظار داشته باشیم: مشکلات تنفسی و علائم عصبی مانند تغییرات بینایی، احساس گیجی، استفراغ، از دست دادن کنترل عضلانی یا تشنج.
هر فردی که این علائم را داشته باشد باید فورا به پزشک مراجعه کند. لازم به ذکر است که همه بیماران نشانه های مشابهی را تجربه نمی کنند. علائم معمولا به صورت خوشه ای ظاهر می شوند و از این رو بهتر است بیمار همیشه با پزشک خود در تماس باشد.
زمانی که به پزشک مراجعه می کنید
چند نکته مفید وجود دارد که ممکن است هنگام ملاقات با پزشک برای بیمار راهگشا باشد:
- با نوشتن سوالات و نگرانی ها از قبل برای قرار ملاقات خود آماده شوید
- از پرسیدن سوالات خود نترسید
- اگر مایل هستید یکی از اعضای خانواده یا دوستانتان را همراه خود ببرید
- از بحث ها، اقدامات و تصمیمات یادداشت برداری کنید
- هر دارویی که مصرف می کنید همراه خود داشته باشید
سوالاتی که باید از پزشک خود بپرسید
- من نگران احتمال سرطان خون هستم، آیا شما آن را رد می کنید؟
- آیا نیاز به آزمایش خون دارم؟
- آیا نیاز به نمونه برداری غدد لنفاوی دارم؟
- آیا به اسکن نیاز دارم؟
- آیا نیاز به نمونه گیری از ادرار وجود دارد؟